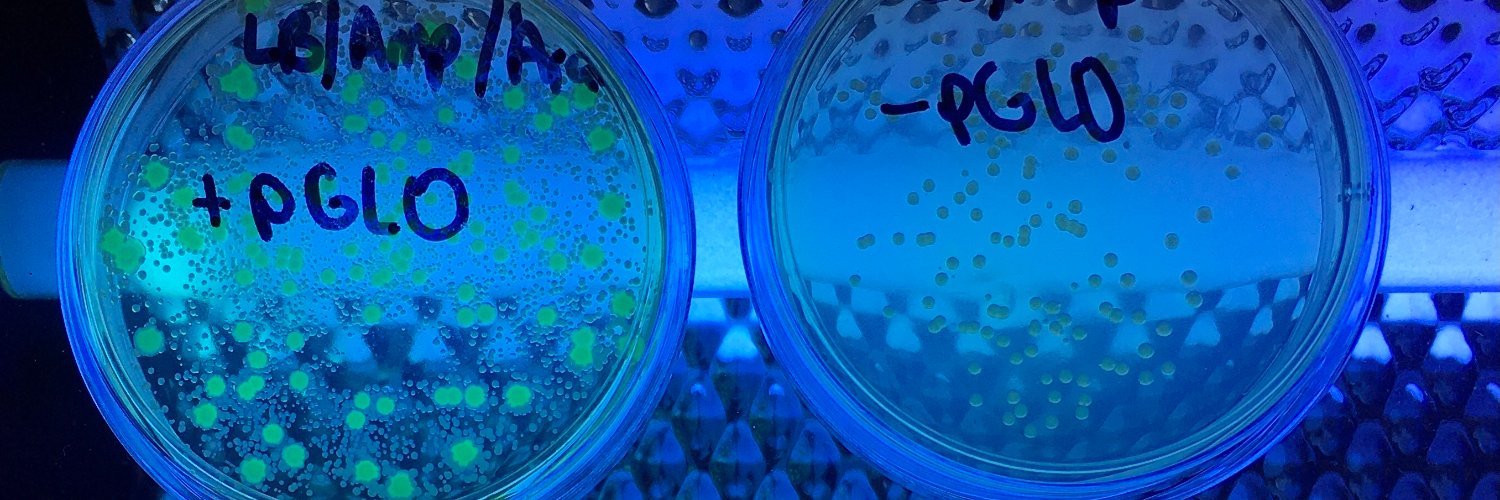
SHS Science banner

Excited to reveal motivational Chemistry activities in a box, designed by Mrs T for @SurbitonHigh outreach programme helping local primary schools. Thrilled to give back to our community. Let us know if we can help you! 🔬🕵️♂️#SHSCommunityAndCharity #ScienceFun




English